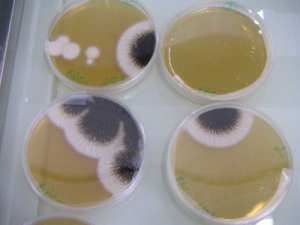

1.3. Les partenaires spécialistes
L'environnement administratif, juridique, technique, matériel de la production de l'information se développe de manière de plus en plus complexe.
L'archiviste a désormais recours à des partenaires spécialistes de leurs domaines, juridique, technique et autres… pour appréhender la complexité de la collecte, du traitement, de la conservation et de la communication des archives contemporaines.
Il s'agit par exemple des informaticiens, des juristes, des techniciens de l'information dont les spécialités se déclinent dans de nouveaux métiers. On peut penser aussi aux métiers liés à la préservation physique des documents, à leur restauration.
Tous apportent une expertise indispensable à l'archiviste pour mieux comprendre les procédures nouvelles de collecte, traitement ou exploitation de l'information.